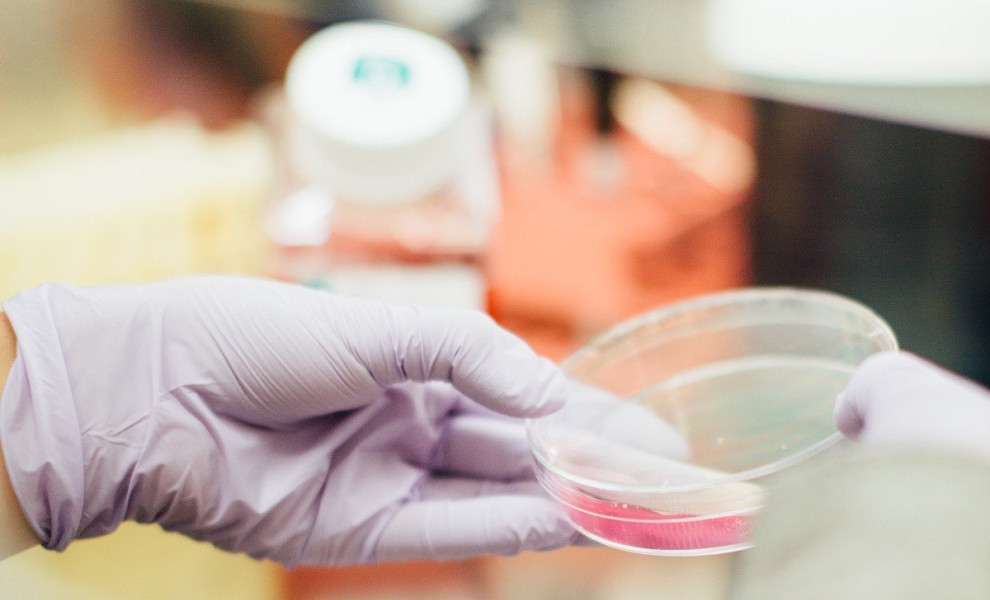
Caption

Τι είναι η βακτηριακή λοίμωξη που οδήγησε τη Μαντόνα στην εντατική - Πως μπορείτε να προστατευθείτε
Βακτηριακή λοίμωξη: Η βασίλισσα της ποπ Μαντόνα νοσηλεύτηκε με σοβαρή βακτηριακή λοίμωξη, όπως έγινε γνωστό την Τετάρτη 28/6.
Ο μάνατζερ της μέσω ανάρτησης στο Instagram ανέφερε ότι, η 64χρονη τραγουδίστρια, εισήχθη στη Μονάδα Εντατικής Θεραπείας (ΜΕΘ) όπου διασωληνώθηκε αφού δεν ανταποκρίθηκε στις αρχικές θεραπείες. Αφού πέρασε λίγες μέρες στη ΜΕΘ, η υγεία της Μαντόνα βελτιώθηκε και αναμένεται να αναρρώσει πλήρως, είπε ο γιατρός της.
Το CNN μετέδωσε τη Πέμπτη πως η τραγουδίστρια πήρε εξιτήριο και αναρρώνει στο σπίτι της. Ωστόσο, δεν είναι σαφές από τι είδους βακτηριακή λοίμωξη προσβλήθηκε η Μαντόνα. Υπάρχουν διάφοροι τύποι βακτηριακών λοιμώξεων, που κυμαίνονται από πνευμονία και μηνιγγίτιδα έως λοίμωξη του δέρματος ή ακόμα και μόλυνση της κυκλοφορίας του αίματος.
«Αυτές οι λοιμώξεις μπορεί να έχουν σοβαρές επιπτώσεις στην υγεία μας, αλλά με ευαισθητοποίηση και προληπτικά μέτρα, μπορούμε να μειώσουμε σημαντικά τον κίνδυνο», είπε ο Δρ. Norman Ng, γιατρός επειγόντων περιστατικών στο Staten Island University Hospital, στο Healthline.
Πώς εξαπλώνεται μια βακτηριακή λοιμώξη
Υπάρχουν διαφορετικοί τρόποι με τους οποίους οι άνθρωποι μπορούν να κολλήσουν μια σοβαρή βακτηριακή λοίμωξη. Το πρώτο είναι μέσω της άμεσης επαφής με ένα μολυσμένο άτομο ή μολυσμένη επιφάνεια που περιέχει επικίνδυνα βακτήρια, λέει ο Ng όπως, κοκκύτης, φυματίωση, στρεπτόκοκκος και μηνιγγιτιδοκοκκική νόσος. Φορείς, όπως τα τσιμπούρια, οι ψύλλοι και τα κουνούπια, μπορούν επίσης να μεταδώσουν βακτήρια στον άνθρωπο δαγκώνοντας το δέρμα μας.
Τα βακτήρια, συμπεριλαμβανομένου του σταφυλόκοκκου, του στρεπτόκοκκου και της ψευδομονάδας, μπορούν να προκαλέσουν λοιμώξεις μετά από χειρουργικές επεμβάσεις. Αυτά τα βακτήρια μπορούν να μολύνουν ένα άτομο μέσω πολλαπλών οδών, συμπεριλαμβανομένων μολυσμένων χειρουργικών εργαλείων ή εξάπλωσης σε μια πληγή μέσω του αέρα ή ενός μολυσμένου ατόμου.
Μια άλλη κοινή οδός είναι η κατανάλωση μολυσμένων τροφίμων και νερού. Για παράδειγμα, μπορείτε να κολλήσετε σαλμονέλα από την κατανάλωση μη καλά μαγειρεμένου κρέατος ή τροφών που περιέχουν κόπρανα από ένα μολυσμένο ζώο. Η λιστέρια είναι μια άλλη βακτηριακή λοίμωξη που μπορεί να προσληφθεί με την κατανάλωση ωμών λαχανικών, κρέατος, μη παστεριωμένου γάλακτος ή επεξεργασμένων τροφίμων, όπως μαλακά τυριά και αλλαντικά, που περιέχουν τα βακτήρια.
Ποιοι είναι πιο επιρρεπείς
Τα άτομα που κινδυνεύουν περισσότερο να προσβληθούν από βακτηριακή λοίμωξη περιλαμβάνουν άτομα με διαβήτη, ηλικιωμένους, έγκυους, μικρά παιδιά και άτομα με εξασθενημένο ανοσοποιητικό σύστημα, συμπεριλαμβανομένων ατόμων με AIDS, που υποβάλλονται σε θεραπείες καρκίνου ή άτομα που έχουν υποβληθεί σε μεταμόσχευση οργάνων.
Τα πρώτα συμπτώματα
Τα πρώιμα σημάδια βακτηριακής λοίμωξης περιλαμβάνουν πυρετό, γαστρεντερικά προβλήματα όπως ναυτία και έμετο, γρήγορο καρδιακό ρυθμό και λιποθυμία. Ο Δρ. Amesh Adalja, ανώτερος μελετητής στο Πανεπιστήμιο Johns Hopkins University Center for Health Security και ειδικός σε μολυσματικές ασθένειες, λέει ότι αυτά τα συμπτώματα μπορεί να αναγκάσουν τους ανθρώπους να αναζητήσουν ιατρική βοήθεια στο τμήμα επειγόντων περιστατικών (ED).
Το πού βρίσκεται η λοίμωξη επηρεάζει τα συμπτώματα που μπορεί να αναπτύξουν οι άνθρωποι. «Για παράδειγμα, τα άτομα με βακτηριακή πνευμονία μπορεί να αποκτήσουν δύσπνοια, κάποιος με βακτηριακή λοίμωξη του ουροποιητικού συστήματος μπορεί να έχει “κάψιμο” με την ούρηση», λέει η Adalja.
Άτομα με βακτηριακές λοιμώξεις μπορεί να εισαχθούν στη ΜΕΘ εάν δεν μπορούν να διατηρήσουν την οξυγόνωση, την αρτηριακή πίεση ή έχουν σοβαρή βλάβη οργάνων. Επιπλέον, σε ορισμένες περιπτώσεις, η μόλυνση μπορεί να εξαπλωθεί στην κυκλοφορία του αίματος και να προκαλέσει σηψαιμία, η οποία μπορεί να απαιτεί εισαγωγή στη ΜΕΘ.
Η σήψη έχει εκτεταμένες επιπτώσεις στο σώμα, συμπεριλαμβανομένης της βλάβης των ιστών, της ανεπάρκειας οργάνων και του θανάτου. Οι βακτηριακές λοιμώξεις συνήθως αντιμετωπίζονται με αντιβιοτικά, τα οποία δρουν σκοτώνοντας τα βακτήρια και εμποδίζοντας την αναπαραγωγή τους, μαζί με υποστηρικτική φροντίδα, λέει ο Adalja.
Οι πάροχοι υγειονομικής περίθαλψης μπορεί να κάνουν μια καλλιέργεια αίματος για να προσδιορίσουν τον τύπο του βακτηρίου που προκαλεί τη μόλυνση. «Η επιλογή του αντιβιοτικού γίνεται πιο συγκεκριμένη με βάση τα αποτελέσματα της καλλιέργειας αίματος», λέει ο Ng.
Ωστόσο, ορισμένα γενικά συμπτώματα μιας βακτηριακής λοίμωξης περιλαμβάνουν:
- πυρετός
- αίσθημα κούρασης
- πρησμένοι λεμφαδένες στο λαιμό, τις μασχάλες ή τη βουβωνική χώρα
- πονοκέφαλος
- ναυτία ή έμετος
Το δέρμα σας είναι η πρώτη άμυνα του σώματός σας έναντι των λοιμώξεων. Τα σπασίματα στο δέρμα, όπως κοψίματα, γρατζουνιές ή χειρουργικές τομές, μπορούν να παρέχουν μια είσοδο στο σώμα για βακτήρια.
Τα συμπτώματα μιας μολυσμένης πληγής μπορεί να περιλαμβάνουν:
- ερυθρότητα στην περιοχή του τραύματος, ιδιαίτερα εάν εξαπλωθεί ή σχηματίσει κόκκινο σημάδι
- πρήξιμο ή ζέστη στην πληγείσα περιοχή
- πόνος ή ευαισθησία στο σημείο του τραύματος ή γύρω από αυτό
- πύον που σχηματίζεται γύρω ή στάζει από το τραύμα
- πυρετός
- πρησμένοι λεμφαδένες στο λαιμό, τις μασχάλες ή τη βουβωνική χώρα
- καθυστερημένη επούλωση πληγών
Πρόληψη
Βεβαιωθείτε ότι ακολουθείτε τις παρακάτω συμβουλές για την πρόληψη βακτηριακών λοιμώξεων:
- Εμβολιαστείτε. Πολλές βακτηριακές λοιμώξεις μπορούν να προληφθούν με εμβόλιο, όπως ο κοκκύτης, ο τέτανος και η βακτηριακή μηνιγγίτιδα.
- Ενυδατώστε το δέρμα σας. Το ξηρό δέρμα μπορεί να σπάσει, κάτι που μπορεί να επιτρέψει στα βακτήρια να εισέλθουν.
- Εφαρμόστε καλή υγιεινή. Πλένετε συχνά τα χέρια σας, ειδικά πριν το φαγητό και μετά τη χρήση του μπάνιου.
- Εάν τα χέρια σας δεν είναι καθαρά, αποφύγετε να αγγίζετε το πρόσωπο, τη μύτη ή το στόμα σας. Το να κάνετε τακτικά μπάνια και ντους μπορεί επίσης να βοηθήσει στην απομάκρυνση των δυνητικά επιβλαβών βακτηρίων από το δέρμα σας.
- Αποφύγετε να μοιράζεστε προσωπικά αντικείμενα. Η κοινή χρήση πραγμάτων όπως οδοντόβουρτσες ή ποτήρια μπορεί να μεταδώσει βακτήρια.
- Μαγειρέψτε το φαγητό στη σωστή θερμοκρασία. Η κατανάλωση ωμού ή μη καλά μαγειρεμένου φαγητού μπορεί να οδηγήσει σε τροφική δηλητηρίαση.
- Διατηρήστε τις πληγές καθαρές. Βεβαιωθείτε ότι οι πληγές καθαρίζονται το συντομότερο δυνατό. Αγγίξτε την περιοχή του τραύματος μόνο με καθαρά χέρια και αποφύγετε το ξύσιμο. Εάν έχετε επίδεσμο, φροντίστε να το αλλάζετε τακτικά ή σύμφωνα με τις οδηγίες του γιατρού σας.
- Χρησιμοποιήστε αντιβιοτική αλοιφή. Εάν έχετε πληγή, η χρήση του Neosporin μπορεί να σας βοηθήσει να κρατήσετε έξω τα βακτήρια. Βεβαιωθείτε ότι εφαρμόζετε μόνο ένα λεπτό στρώμα στο σημείο με καθαρά χέρια.
- Κάντε ασφαλές σεξ. Πολλές σεξουαλικά μεταδιδόμενες λοιμώξεις, όπως η γονόρροια και τα χλαμύδια, προκαλούνται από βακτήρια. Να φοράτε προφυλακτικό και να κάνετε τακτικές εξετάσεις.







